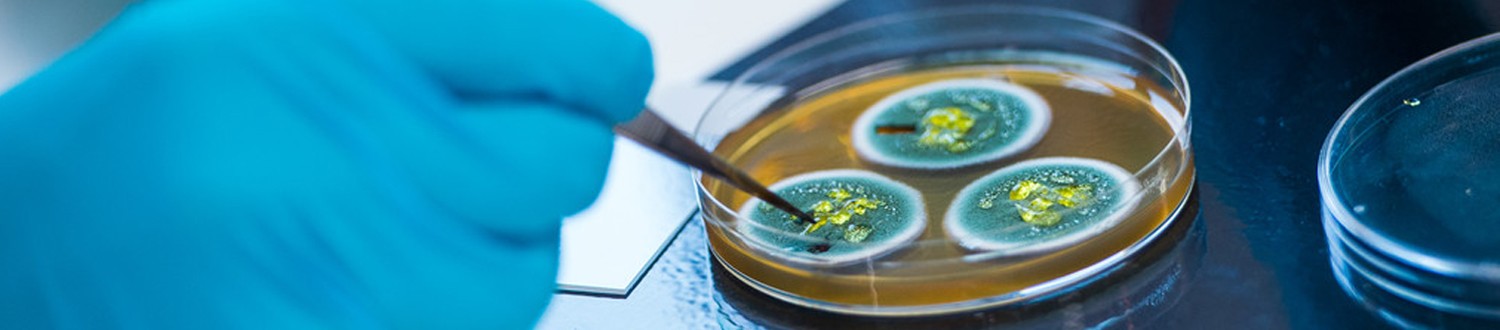
Hand working on petri-dish

Strategic Research Theme: Lifelong Health
Lifelong Health is one of the University of Surrey’s strategic research themes which has been defined to support the ambitious objectives for research excellence and impact.
Aims and objectives
The Lifelong Health research theme will promote interdisciplinary research across the spectrum from discovery science to population-based studies of health, wellbeing and care in both humans and animals. A life-course approach adopts a temporal and socially just perspective of healthy ageing, from conception onwards, working at and integrating multi-level approaches from molecular, cellular, and organ systems, to behavioural/psychological and social/environmental approaches to advance health and wellbeing throughout the life course and at critical transition points.
Through imagining plausible and desirable futures and designing and delivering social and technological solutions to realise them, we will address the causes and improve the management of ill-health in an ageing society to reduce pressure on health and social care systems through innovation.
Our researchers are committed to working with colleagues in academia, in industry, in policy-making fields and in public discussion groups to ensure our real-world impact draws from broader experience and serves local, national and international health needs.
Ctrl, alt, delete. How do we reboot our way of living and society after COVID-19?
Could the pandemic re-shape our world for the better? Clean recovery and growth, kick starting economies, new vaccine technology, AI replacing workers - can they really mean a better world where things we only dreamt of barely a year ago become reality in the coming months and years?
Theme champion
Professor Deborah Dunn-Walters
Professor of Immunology, Associate Dean Research and Innovation